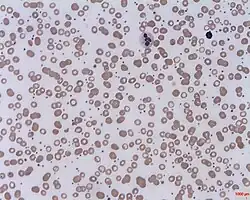
Ilustracja

Nadpłytkowość samoistna
| thrombocytosis essentialis | |
Trombocytoza | |
| Klasyfikacje | |
| ICD-10 |
D75.2 |
|---|---|
| ICDO |
M9962/3 |
| DiseasesDB | |
| MedlinePlus | |
| MeSH | |
Nadpłytkowość samoistna (łac. thrombocytosis essentialis, ang. essential thrombocytosis) – choroba polegająca na patologicznym wzroście trombocytów zaliczana do zespołów mieloproliferacyjnych.
Epidemiologia
Głównie u osób w wieku 50-60 lat bez zróżnicowania pod względem płci. Częstość zachorowań wynosi około 1:100 000/rok.
Etiopatogeneza
Nadmierne płytkotworzenie (nawet 10-krotny wzrost) powodujące zwiększenie ilości i całkowitej masy megakariocytów. Powstałe płytki mają nieprawidłową budowę i zaburzoną funkcjonalność.
Objawy
- zmiany zakrzepowe powodujące:
- bóle i zawroty głowy
- parestezje
- przemijające niedowłady
- zaburzenia wzrokowe
- napady padaczkowe
- zgorzel
- erytromelalgia
Zmiany zakrzepowe pojawiają się głównie w małych naczyniach, ale mogą także obejmować duże naczynia tętnicze i żylne.
- skaza krwotoczna
- krwawienia w przewodu pokarmowego
- krwawienia z dróg moczowych
- krwawienia z nosa, dziąseł i do gałki ocznej
- krwotoki mózgowe
- powikłania krwotoczne po zabiegach chirurgicznych
- stany podgorączkowe
- chudnięcie
- zlewne poty
- świąd skóry
- splenomegalia
- niekiedy hepatomegalia
Badania pomocnicze
- liczba trombocytów - zwykle w granicach 1 000 000/μl - 2 000 000/μl (1000-2000 G/l)
- w rozmazie krwi obwodowej:
- skupienia płytek, płytki olbrzymie, fragmenty jąder megakariocytów
- pojedyncze mielocyty, metamielocyty, eozynofilia, bazofilia
- zwiększona komórkowatość szpiku - hiperplazja megakariocytów o nieprawidłowym kształcie i funkcjonalności
- wydłużenie czasu krwawienia
- zaburzenia agregacji płytek
- skaza krwotoczna spowodowana nabytym zespołem von Willebranda - adsorpcja czynnika von Willebranda na płytkach i jego usuwanie z krążenia
- wzrost stężenia kwasu moczowego, LDH i poziomu witaminy B12 w surowicy
- pseudohiperkaliemia - uwalnianie in vitro potasu z płytek krwi
- pseudohipoksja - wywołana zużywaniem przez trombocyty tlenu
Kryteria rozpoznania
| Lp. | Kryterium |
|---|---|
| 1 | liczba płytek krwi > 600 000/μl (600 G/l) stwierdzona dwukrotnie w odstępie miesiąca |
| 2 | wykluczenie nadpłytkowości wtórnej |
| 3 | prawidłowa objętość masy erytrocytarnej (mężczyźni <36 ml/kg mc.; kobiety <32 ml/kg mc.) |
| 4 | brak włóknienia szpiku |
| 5 | nieobecność chromosomu Philadelphia lub fuzji genu BCR/ABL |
| 6 | splenomegalia |
| 7 | zwiększona komórkowatość szpiku z hiperplazją megakariocytów i obecnością agregatów megakariocytarnych |
| 8 | wykluczenie niedoboru Fe (prawidłowa zawartość syderoblastów w szpiku i prawidłowe stężenie ferrytyny w surowicy) |
| 9 | u kobiet wykazanie klonalnego charakteru hematopoezy (analiza genów zawartych na chromosomie X) |
| 10 | obecność nieprawidłowych komórek prekursorowych ze zwiększoną wrażliwością na działanie interleukiny 3 |
| 11 | prawidłowe stężenie CRP i interleukiny 6 |
Rozpoznanie przesądza spełnienie kryteriów 1-5 + przynajmniej trzech spośród kryteriów 6-11.
Rozpoznanie różnicowe
- nadpłytkowość wtórna - zwłaszcza w przebiegu chorób zapalnych i nowotworowych
- inne zespoły mieloproliferacyjne - czerwienica prawdziwa, przewlekła białaczka szpikowa, osteomieloskleroza
- zespoły mielodysplastyczne - głównie zespół 5q- i nabyta niedokrwistość syderoblastyczna
Leczenie
- trombocytofereza - w stanach naglących
- Anagrelid (hamuje dojrzewanie megakariocytów), przy braku tolerancji tego leku - interferon α
- hydroksykarbamid - głównie u osób starszych
- busulfan, cyklofosfamid, CCNU, radioaktywny fosfor - ostrożnie, gdyż istnieje możliwość wystąpienia wtórnej białaczki
- kwas acetylosalicylowy lub tiklopidyna - w przypadku przebytych incydentów zakrzepowo-zatorowych, TIA lub erytromelalgii
- przetoczenie koncentratu płytek - w przypadku skazy krwotocznej
- DDAVP - przy nabytym zespole von Willebranda
Rokowanie
10 lat przeżywa 64-80% chorych. U 3-10% rozwija się ostra białaczka. U 6% pojawia się zwłóknienie szpiku kostnego.
Bibliografia
- Włodzimierz Januszewicz, Franciszek Kokot, Witold Bartnik: Interna. 2. Warszawa: Wydaw. Lekarskie PZWL, 2004, s. 839-840. ISBN 83-200-2872-8 (t. 2).
- Gerd Herold, Jan Duława: Medycyna wewnętrzna : repetytorium dla studentów medycyny i lekarzy. Warszawa: Wydawnictwo Lekarskie PZWL, 2005, s. 101. ISBN 83-200-3322-5.
Linki zewnętrzne
- THROMBOCYTHEMIA, ESSENTIAL w bazie Online Mendelian Inheritance in Man (ang.)
![]() Przeczytaj ostrzeżenie dotyczące informacji medycznych i pokrewnych zamieszczonych w Wikipedii.
Przeczytaj ostrzeżenie dotyczące informacji medycznych i pokrewnych zamieszczonych w Wikipedii.